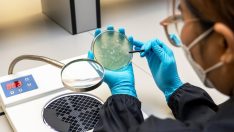
Uzmanlar uyardı… Et yiyen ölümcül bakteri en yüksek seviyede

SON DAKİKA
13:57 BAHARA BOSSA NOVA DOKUNUŞU
07:25 SINAV DÖNEMİNDE KONTROLSÜZ İLAÇ KULLANIMI ALARM VERİYOR
07:24 ECE VAHAPOĞLU’NA ‘GELİN TAKIMI 3’ SÜRPRİZİ
13:12 ‘SONSUZ GÜZEL’ FİLMİNDE BAŞROL FERHAN VURAL’IN
13:11 YAŞAM ALIŞKANLIKLARINDAKİ DEĞİŞİKLİKLERLE ÖNLEMEK MÜMKÜN
13:09 DEFNE SAMYELİ, TÜRK KLASİK MÜZİĞİ VE CAZIN BULUŞTUĞU ÖZEL BİR ALBÜM YAYINLADI
08:40 ATİYE BAHARI SAHNEDE BAŞLATTI
08:39 FATİH’İN ASLANI HOLLANDA’LI RAKİBİ SAMED STOKEY İLE DÖVÜŞECEK